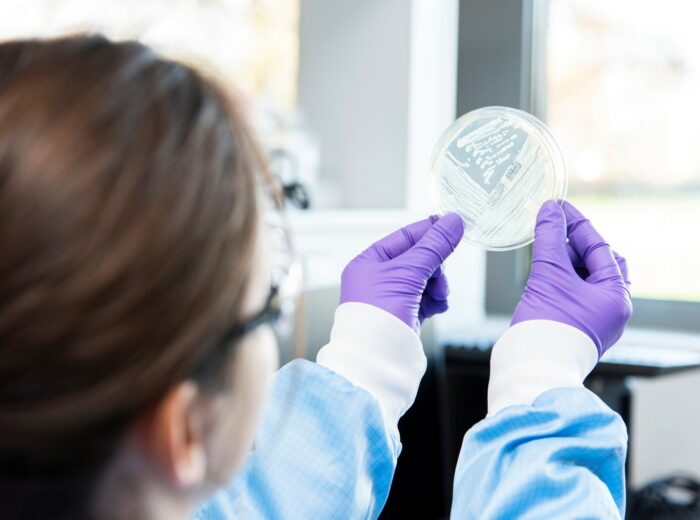

Contrôle qualité, biosécurité, caractérisation : une expertise au cœur des biothérapies
Société spécialisée dans le contrôle qualité des produits biologiques et pharmaceutiques, Clean Cells intervient sur quatre grands segments : vaccins, protéines recombinantes, thérapies cellulaires et thérapies géniques. Forte de près de 140 collaborateurs, renforcée par l’acquisition de Karyologic aux États-Unis, l’entreprise fait partie (avec la société Naobios) du groupe Clean Biologics, avec une présence et un portefeuille de clients à l’échelle internationale, majoritairement en Europe.
Le cœur historique de son activité repose sur le « biosafety testing », indispensable pour garantir la sécurité des produits destinés aux patients. Les équipes recherchent l’ensemble des contaminants potentiels : bactéries (tests de stérilité), mycoplasmes, mycobactéries, virus adventices. Ces analyses s’inscrivent dans un environnement hautement réglementé, régi par les pharmacopées européennes et américaines, imposant des méthodes validées, reproductibles et conformes aux standards internationaux.
Au-delà des méthodes traditionnelles (culture, inoculation, PCR), Clean Cells intègre les dernières évolutions technologiques, notamment le séquençage haut débit (NGS), générant de nouveaux volumes de données et de nouveaux enjeux d’interprétation. « L’objectif est de disposer de la boîte à outils la plus complète possible pour proposer les tests les plus pertinents », résume Marc Meichenin, co-fondateur et directeur scientifique de Clean Cells.
Un accompagnement sur toute la chaîne de valeur biopharmaceutique
Clean Cells accompagne une grande diversité d’acteurs : biotechs, CDMO, groupes pharmaceutiques. Son positionnement : intervenir du très « early stage » en R&D jusqu’à la commercialisation, en passant par les phases précliniques et cliniques.
Cette approche globale inclut aussi la caractérisation fonctionnelle des produits (potency assays), visant à démontrer leur activité biologique. Un enjeu majeur pour des thérapies complexes comme les CAR-T cells ou les vecteurs de thérapie génique, où il s’agit de prouver que le produit délivrera bien l’effet thérapeutique attendu.
Autre pilier stratégique : la production de starting materials, notamment les banques cellulaires (Master Cell Banks, Working Cell Banks) et virales (Master and Working Virus Seeds Stocks), fabriquées en environnement contrôlé. Véritable “matière première” des bioproductions, elles nécessitent des conditions strictes : salles propres, congélation contrôlée, répartition sécurisée. Une expertise qui complète l’offre analytique.
Enfin, Clean Cells se distingue par une forte activité de conseil scientifique et réglementaire en aidant ses clients à définir leurs stratégies de contrôle qualité, anticiper les exigences et adapter les protocoles à leurs contraintes de développement.
Une aventure entrepreneuriale née de la recherche… et d’un écosystème
L’histoire de Clean Cells débute en 2000 avec trois fondateurs issus de la recherche académique : Marc Meichenin et Frédéric Henry, spécialistes de l’immunothérapie du cancer, et Olivier Boisteau, expert en pharmacologie cellulaire. Tous trois constatent l’impact des contaminations, notamment les mycoplasmes — sur la fiabilité des travaux scientifiques et décident de créer une entreprise dédiée à leur détection et à la sécurité biologique des produits biopharmaceutiques.
Lauréats du Tremplin Aventis – Institut de France sous l’égide d’Axel Kahn, ils fondent Clean Cells en juillet 2000. La société bénéficie à ses débuts du soutien de la Fondation Aventis – Institut de France pour ses premiers développements, ainsi que de l’association Ouest-Entreprendre.
Une première étape structurante est franchie en 2003 avec l’ouverture du capital. Plusieurs investisseurs régionaux accompagnent alors la croissance de l’entreprise : Pays de la Loire Développement (devenu depuis Sodero), Océan Participations (filiale du Crédit Mutuel) ainsi que TOD Finances, un business angel. Ce premier tour de table permet notamment à Clean Cells de se doter d’infrastructures plus adaptées à ses activités, incluant un laboratoire de niveau L3.
L’entreprise traverse ensuite différentes phases de développement, soutenue par des investisseurs régionaux et nationaux, jusqu’à son intégration en 2018 au sein du groupe Clean Biologics, majoritairement détenu par le fonds d’investissement ArchiMed. Cette opération marque une nouvelle accélération de sa stratégie de croissance et de structuration à l’échelle internationale.
L’écosystème territorial joue un rôle clé dès l’origine de Clean Cells. Atlanpole accompagne la structuration du business plan et la création de l’entreprise. Par la suite, plusieurs projets sont labellisés par Atlanpole Biotherapies, notamment dans le cadre d’appels à projets collaboratifs (ex. Hybrid ADCC, projets liés à la bioproduction France 2030). Clean Cells collabore également avec des acteurs industriels comme Vivalis (devenu Valneva).
Le développement de Clean Cells s’appuie aussi sur un ancrage territorial fort et sur l’engagement d’acteurs publics et privés mobilisés aux côtés de l’entreprise, parmi lesquels la Région Pays de la Loire, la Ville de Boufféré puis Montaigu, des fonds régionaux ou encore Ouest Entreprendre. Cette dynamique s’illustre pleinement dans la construction du nouveau bâtiment « state of the art » en Vendée, livré en 2022 et opérationnel depuis 2023. Clean Cells a fait le choix stratégique de s’entourer largement de partenaires locaux pour mener à bien ce projet structurant, témoignant de sa volonté de faire travailler l’écosystème régional. L’entreprise tient notamment à saluer l’implication de Laporte Euro (également membre d’Atlanpole Biotherapies) dont l’expertise dans la conception et la construction de laboratoires pharmaceutiques a contribué de manière déterminante à la réussite du site, aux côtés de l’ensemble des entreprises mobilisées.
Un webinaire pour mieux anticiper le contrôle qualité
Fort de cette expertise, Clean Cells porte un message central à la filière : le contrôle qualité doit être anticipé très en amont des projets biothérapeutiques.
Anticiper, c’est :
- prévoir les besoins en échantillons,
- intégrer les coûts analytiques,
- sécuriser les étapes réglementaires,
- éviter les retards de développement.
C’est tout l’enjeu du webinaire organisé le 5 mars 2026 par Clean Cells et Atlanpole Biotherapies, consacré à l’anticipation du contrôle qualité et du biosafety testing pour sécuriser les projets biotech.
Cette première session avait pour objectif de sensibiliser les porteurs de projets et les acteurs biotech et pharma du Grand Ouest, en leur apportant une vision claire, accessible et pragmatique du contrôle qualité afin de mieux l’intégrer dès les phases amont et d’éviter les écueils fréquents rencontrés lors du développement.
Le webinaire est désormais disponible en replay sur la chaîne YouTube d’Atlanpole Biotherapies : https://www.youtube.com/watch?v=oDYSu22bP7A
Une initiative qui illustre pleinement la mission partagée par Clean Cells et Atlanpole Biotherapies : éclairer, structurer et sécuriser le développement des biothérapies, au bénéfice des patients comme de la compétitivité de la filière.